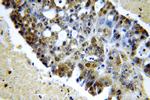
SPIN1 Antibody in Immunohistochemistry (Paraffin) (IHC (P))

Search
Proteintech
SPIN1 Polyclonal Antibody
{{$productOrderCtrl.translations['antibody.pdp.commerceCard.promotion.promotions']}}
{{$productOrderCtrl.translations['antibody.pdp.commerceCard.promotion.viewpromo']}}
{{$productOrderCtrl.translations['antibody.pdp.commerceCard.promotion.promocode']}}: {{promo.promoCode}} {{promo.promoTitle}} {{promo.promoDescription}}. {{$productOrderCtrl.translations['antibody.pdp.commerceCard.promotion.learnmore']}}
产品信息
19531-1-AP
种属反应
已发表种属
宿主/亚型
分类
类型
抗原
偶联物
形式
浓度
规格
纯化类型
保存液
内含物
保存条件
运输条件
产品详细信息
This antibody is specific to spindlin 1 (SPIN1), not to other spindlins, such as SPIN2 and SPIN3.
靶标信息
SPIN1 (spindlin 1), also known as SPIN or ovarian cancer-related protein (OCR), is a 262 amino acid nuclear protein suggested to play a role in regulation of the cell-cycle during the transition from gamete to embryo. A member of the SPIN/STSY family, SPIN1 localizes to interphase nucleus and mitotic chromosomes, and is modified by phosphorylation in a cell-cycle-dependent fashion. A meiotic spindle-binding protein, SPIN1 overexpression has been shown to cause defects in mitotic spindles, thereby resulting in chromosome instability and potential tumorigenesis.
仅用于科研。不用于诊断过程。未经明确授权不得转售。
生物信息学
蛋白别名: ovarian cancer-related (OCR) protein; Ovarian cancer-related protein; SPIN; Spindlin-1; Spindlin1; unnamed protein product
基因别名: OCR; SPIN; SPIN1; TDRD24
UniProt ID: (Human) Q9Y657
Entrez Gene ID: (Human) 10927